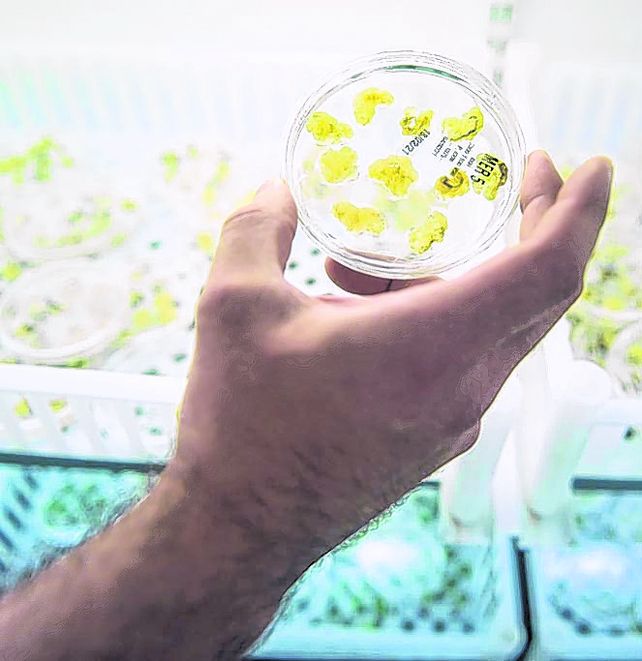
Academia. Las bio tienen gran vinculación con organismos públicos. Academia. Las bio tienen gran vinculación con organismos públicos.

Argentina se ubica entre los 10 países con más empresas de biotecnología del mundo, un sector que registró un fuerte crecimiento y una marcada orientación hacia el sector agropecuario, agroindustrial y de la salud humana. En ese universo, Santa Fe está en un lugar de jerarquía, entre los tres primeros distritos donde prendió fuerte la economía del conocimiento, actualmente el tercer rubro de exportación del país el año pasado, con más de 7.500 millones de dólares.
El sector agropecuario colonizó el universo de firmas biotecnológicas
Por Sandra Cicaré
El estudio remarca la importancia de la transferencia.
Academia. Las bio tienen gran vinculación con organismos públicos.
El 1º Censo Nacional de Empresas de Bio y Nanotecnología se presentó en la agencia I+D+i.
Empresas en su mayoría nacidas en forma independiente, de pequeña escala, con un fuerte sello agropecuario, marcado perfil exportador y creadoras de empleo calificado, conforman el universo de las firmas de bio y nanotecnología relevadas en el 1º censo argentino sobre el sector. Un trabajo donde, al igual que en las empresas, se expresó un claro vínculo entre lo público y lo privado. Lo desarrollaron la Agencia de I+D+i, la Cámara Argentina de Biotecnología, la Fundación Argentina de Nanotecnología junto al Consejo Federal de Inversiones, el Cenit de la Universidad de San Martín (Unsam), el cluster de biotecnología de Córdoba y el Hub Bio Santa Fe.
La muestra detectó que así como la mayoría de las empresas tienen vinculación con estamentos públicos como universidades y organismos _especialmente las bio_ para llevar a delante sus acciones de investigación y desarrollo y testeos de ensayos, en general se detectó una baja utilización de los regímenes de promoción sectoriales contemplados en leyes como la de economía del conocimiento, de biotecnología moderna o de promoción de bio y nanotecnología, que tuvieron un fuerte impulso durante este gobierno.
El relevamiento permite al sector tener un mapa claro de la evolución que tuvo la actividad, especialmente después del año 2015 cuando hubo un repunte que se sostuvo en el tiempo hasta 2023, especialmente de nuevas firmas orientadas a I+D. Este insumo público también busca hacer un aporte concreto para la definición de políticas públicas.
El censo, que fue presentado por Lilia Stubrin de la Unsam, mostró que en Argentina hay identificadas 340 empresas de biotecnología, 77 de ellas, es decir el 22%, están radicadas en Santa Fe, provincia que representa el tercer distrito luego de Buenos Aires y Ciudad Autónoma de Buenos Aires (Caba) en cantidad de empresas. Ese número ubica al país en el puesto número 10 a nivel internacional, un ránking que está liderado por Estados Unidos, Francia, Canadá y España en los primeros cuatro puestos, pero por arriba de Noruega, Portugal, o Brasil, en cuyo caso hay detectadas 190 compañías del sector.
Sobre el total de firmas identificadas y a los efectos del trabajo metodológico, los investigadores relevaron 210 empresas.
Aunque las empresas de biotecnología incluyen actividades vinculadas con la nanotecnología, el censo separó los universos de estudio para caracterizarlos por sector. En ese caso, se identificaron 34 firmas exclusivamente dedicadas a la nano, de las cuales el 40% está ubicada en Buenos Aires, el 27% en Caba, 12% en Córdoba y 6% en Santa Fe. Sobre ese total, se relevaron 24.
En ambos casos, los sectores de mayor desarrollo son los vinculados a la biotecnología agropecuaria, tanto en los estadios de I+D como en el precomercial o de mercado, 77 sobre 210. Luego le siguen salud humana (73 empresas), procesamiento industrial (41), salud animal (41), ambiente, energía y recursos naturales (26) y el resto 49, que se dedican a aplicaciones no específicas u otros rubros.
El peso del sector agropecuario
Por otra parte, la biotecnología agropecuaria y los bioinsumos y la micropropagación vegetal es el segmento al que se dedican mayoritariamente las empresas de biotecnología. También es el rubro que concentra mayor número de lanzamientos en el mercado, frente a aquellas áreas que aún siguen en etapa de I+D o experimentación o escalado. Por caso, el censo muestra que en el segmento bio, 24 empresas están con productos en el mercado, 44 en etapa de I+D y 38 en experimentación.
“El sector está creciendo de manera dinámica y genuina, y la economía del conocimiento es el tercer rubro de exportación en la Argentina con más de 7.500 millones de dólares”, dijo el presidente de la Agencia I+D+i, Fernando Peirano quien ante el cambio de gobierno se despidió de su gestión al frente del organismo y señaló que el censo “permite tener un mapa de actores, inversiones, impacto y oportunidades que genera el sector”.
“Estamos convencidos que los nuevos desarrollos también necesitan de nuevos actores, como las start up y empresas de base tecnológica (EBT) que estan llegando. Eso crea riqueza y valor agregado”, indicó.
De hecho, en el pipeline de la actividad, las nuevas empresas creadas en los últimos siete años representan el 50% y ese número se duplica en el caso de las nano, especialmente bajo el modelo de start ups.
También Peirano resaltó que este censo se trata de un “bien público“ que es “indispensable para elevar la calidad de la discusión”. Destacó que desde la Agencia I+D+i se acompañó el impulso del sector con acciones orientadas a promover el desarrollo de la bio y nanotecnología “por más de 3.800 millones de pesos durante 2023, en el marco del Programa Federal de promoción de la Biotecnología y la Nanotecnología”.
“Es la primera vez que más allá de lo cualitativo tenemos un número para contar, sobre ventas, empleados, potencial exportador, algo esencial para elaborar políticas es fundamental, era algo que no teníamos”, aseveró Laura Toledo, vicepresidenta de la Fundación Argentina de Nanotecnología (FAN).
Empleo, ventas y exportación
“Lo que no se mide no existe” aseguró Federico Trucco, presidente de la Cámara Argentina de Biotecnología, al valorar el aporte del censo y dijo que es difícil que “otra industria pueda mostrar semejante evolución”.
Los datos duros muestran que las 210 compañías biotecnológicas relevadas emplean 15.222 personas y si ese número se extrapola al total de identificadas (340), ese número llegaría a 19.821 puestos de trabajo. En el caso de las nanotecnológicas, las 24 relevadas emplean a 691 trabajadores, y si se extrapola al total (34) llegarían a 961 empleos. En la mayoría de los casos se trata de trabajo calificado, especialmente títulos de grado, doctorados y post doctorados. “Si se observa el universo nano, en las empresas creadas luego de 2015 crece el personal más formado”, indicó.
Pero además de generador de empleo, el sector es proveedor de divisas. En 2022 las 210 empresas de biotecnología exportaron por u$s 387 millones. “Si se extrapola a las 340 identificadas, ese numero llegaría a u$s 708 millones”, detalló Stubrin. Las 24 nanotecnológicas relevadas, exportaron el año pasado por u$s 283 millones.
Por otra parte, las ventas totales de las biotecnológicas ascendieron a u$s 3.363 millones el año pasado y la de las nano alcanzaron los u$s 275 millones.
Además, el universo relevado es un sector con creciente internacionalización. Sobre el universo de bio, 56 tienen empresas subsidiarias, la mayoría en Estados Unidos (21) y el resto en Brasil y otros países de América latina.
También son compañías que avanzan en el patentamiento de sus desarrollos. Unas 77 bio tienen solicitudes de patentes en Argentina, 66 en EEUU, 33 en Europa y 15 en Brasil. En las nano el número alcanza a 35 en el país, 1 en Brasil, 3 en EEUU y 2 en Europa.
“Hay 16 start ups relevadas que en menos de dos años solicitaron patentes en el exterior y se duplicó la participación de patentes en biotecnología, hay casi 1.000 por año”, enfatizó Trucco. “Si esto se logra a pesar de las dificultades que tenemos lo que podríamos lograr empezando a resolver los puntos débiles”, agregó.
Los puntos críticos
En ese sentido, el censo identificó que entre los principales problemas que plantean las empresas bio y nano, se encuentra el contexto macroeconómico (85%) como la incertidumbre económica financiera y las dificultades para la importación. El 73% de las firmas planteó problemas con el financiamiento a la innovación; el 62% con infraestructura y equipamiento de I+D y para escalado; el 60% por cuestiones regulatorias, como largos tiempos de aprobación o encuadramiento o altos costos; y el 51% se quejó por los procesos burocráticos, como dificultades para realizar acuerdos de I+D con organizaciones de CyT por falta de agilidad en los procesos contractuales.
Finalmente, el 71% de las bio innovaron en productos, un 48,6% para el mercado internacional, y el 56% en procesos y el 31,2% para plazas externas.
En cuanto a las nanotecnológicas, 71% innovaron en productos y de ese número 46,6% para el mercado externo, mientras que el 47% lo hizo en procesos y el 50% de los casos para las plazas internacionales.
Por otra parte, la mayoría de las empresas biotecnológicas tiene vinculación muy marcada con universidades públicas y otros organismos de CyT de Argentina (41,9% y 45,7% respectivamente), especialmente para actividades de I+D conjuntas y testeo, pruebas y ensayos. Luego, en el resto de los pasos, el vínculo es con la cadena de valor.
En cambio, las nano se vinculan para actividades de I+D y transferencia de conocimientos a terceros, con la cadena de valor y para testeo, pruebas y ensayos, con organismos públicos.
“Esto es el reflejo de una comunidad de profesionales que creen en la ciencia y la tecnología como motor imprescindible para el desarrollo que dará resolución a los problemas que enfrentamos”, sintetizó Peirano. “Academia, start ups, organizaciones empresariales, todos forman un hilo común con la idea de la transformación basada en el conocimiento”, concluyó.